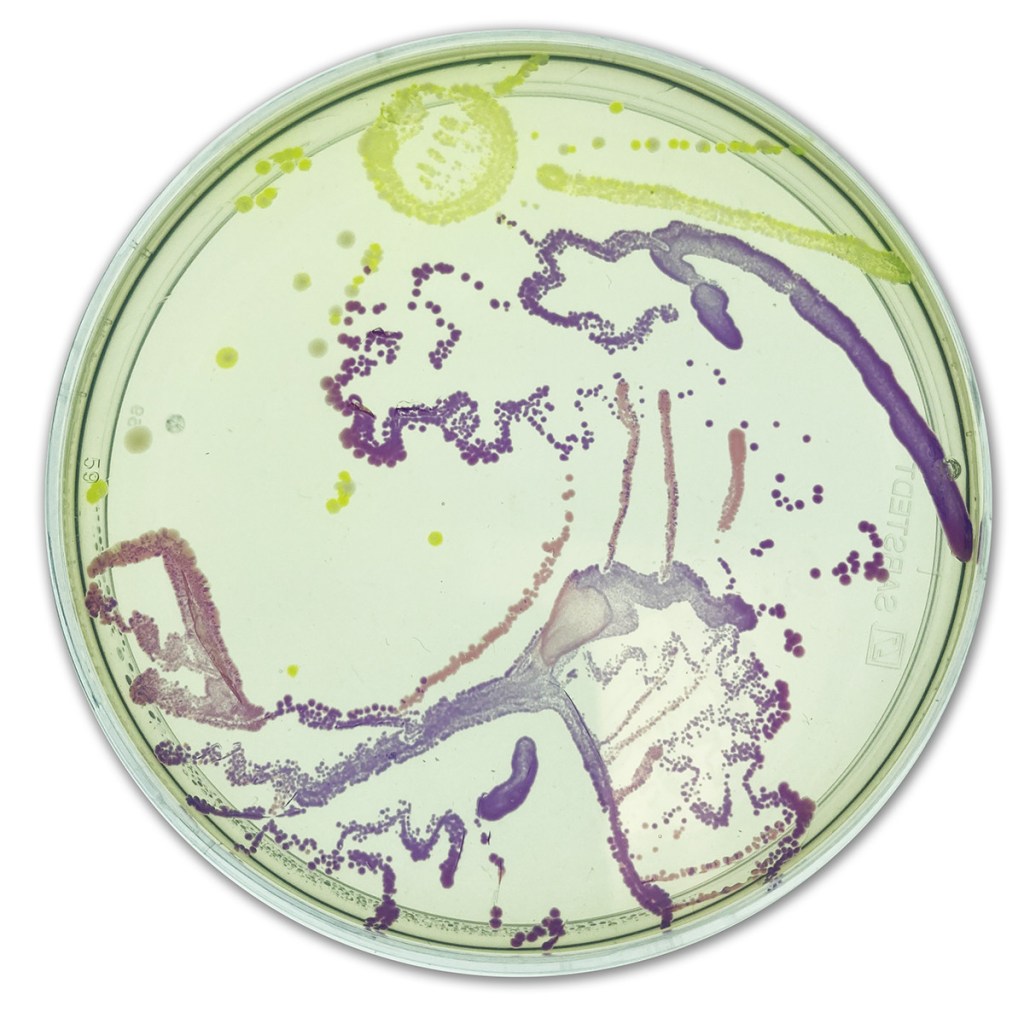

This is a guest post from Dr. Geoff Hunt, Public Outreach Specialist at the American Society for Microbiology. You can find him on Twitter at @TheGeoffHunt.
Microbiologists have been using agar petri dishes as artistic canvases for decades, so the American Society for Microbiology can’t claim to be original. All we did was to provide a platform to showcase these works of art in the form of our annual Agar Art contest, which is now recognized as one of the premier opportunities for science engagement.
Ever since the Agar Art contest began in 2015, scientists and educators from around the world have been using the Agar Art contest as a platform to demonstrate the connection between art and science. In the past 6 years, we’ve received more than 1200 submissions from participants in over 100 countries. Winners have included original creations that focus on topics ranging from microbiomes to sea life to infection and disease, along with interpretations of well-known works of art, such as Edward Munch’s “The Scream.”
We at ASM view the Agar Art contest as a true educational opportunity, one that promotes the use of art to share, inspire and teach about science. While the artwork gets the headlines, the contest does contain a strong scientific component- each submission must be accompanied by a detailed explanation of the various microbial strains and media used to create the artwork. This text is judged as part of the entry, alongside the creative features.
Feedback from past participants suggests that the chance to show off their artistic skills is what primarily drives submissions. Of course, the competition aspect doesn’t hurt. Students up to the age of 12 can win up to $50 by submitting entries in the “Kids” category, while older students (and adults) are eligible to compete in the “General” category, with a chance to win up to $200.
Perhaps even more impactful is the exposure winning entries receive through the extensive media coverage the contest receives. The Agar Art contest has been featured in pieces in National Geographic and the Smithsonian Magazine, and in the past year, articles about winning submissions have appeared in publications based in India, England and South Korea.
ASM also partners with the Liberty Science Center in New Jersey on their “Microbes Rule!” permanent exhibit, which provides a large display of contest entries. Each year, the display is updated with that year’s winners, providing yet another outlet for exposure.
Our ultimate goal for the Agar Art contest is to continue its growth, exposing more and more people (students, educators, scientists and non-scientists alike) to microbiology. Given that perspective, we are always looking to generate more submissions from different stakeholders. That’s why we’re excited to partner with Edvotek on their Agar Art kit – we realize that not every classroom or school has access to the wealth of material that is typically found in a research laboratory, so these ready-made materials provide a straightforward way for educators and students to produce Agar Art works.
This year’s Agar Art contest will launch on September 10 and run through the end of October. Stay tuned to the contest website for announcements, and be sure to follow ASM on social media (@ASMicrobiology on Twitter/Instagram, American Society for Microbiology on Facebook) for updates. As a bonus, as part of this year’s contest, Edvotek will be giving away two free kits to their followers (details will be available on both the ASM and Edvotek websites).
In the meantime, I’m always happy to answer any contest-related questions. We hope you are inspired to encourage your students to submit an entry (or submit one yourself)!



